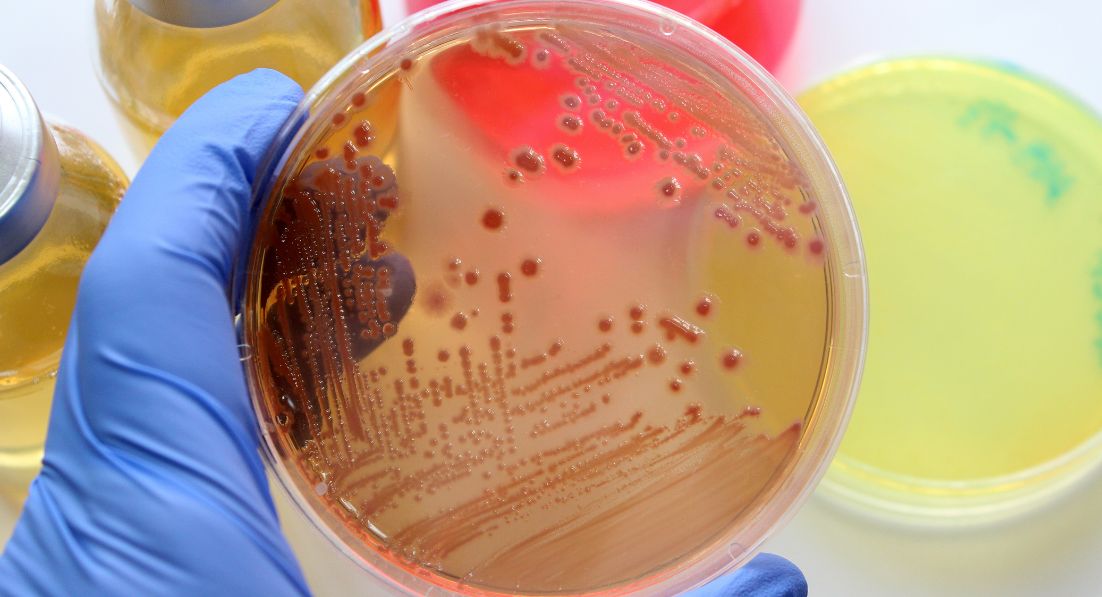

INFORMACIÓN SOBRE PROTECCIÓN DE DATOS
Los datos personales que facilite serán tratados por el Ilustre Colegio Oficial de Médicos de Madrid (ICOMEM), con el fin de gestionar su solicitud, dar cumplimiento a las leyes de colegios profesionales, así como a los propios estatutos del ICOMEM, facilitando la gestión de las diferentes actividades llevadas a cabo por el ICOMEM.
Además de la correspondencia que estatutariamente deba remitirse desde el Colegio a fin de mantenerle informado de las actividades y servicios comunes de interés para los colegiados, sus datos serán tratados, si lo desea, para recibir periódicamente comunicaciones informativas, por vía electrónica o convencional, de carácter profesional, formativo, cultural, asistencial, económico, de previsión u análogos, que a juicio del ICOMEM pudieran resultar de su interés, autorizando expresamente el tratamiento de sus datos para esta finalidad.
Asimismo, le informamos que sus datos profesionales (por ejemplo, número de colegiado, fecha de incorporación, situación de ejercicio profesional, teléfono fijo o móvil, domicilio profesional, correo electrónico, todos éstos de carácter profesional, así como, en su caso, horario de trabajo o consultas) serán incluidos en el censo de colegiados o guía colegial que, en su caso, fuere editada en papel y/o electrónicamente a través del sitio web
www.icomem.es.
La base jurídica para el tratamiento de los datos personales dependerá de los datos personales implicados y de la actividad de tratamiento en cuestión. Así, podemos tratar su información personal sobre la base de: i) el cumplimiento de una misión realizada en interés público o en el ejercicio de poderes públicos conferidos al responsable del tratamiento (ordenación profesional y control deontológico); ii) el consentimiento del colegiado; iii) satisfacción de intereses legítimos perseguidos por el responsable del tratamiento; o iv) el cumplimiento de una obligación legal (derivadas de la Ley 2/1974 de Colegios Profesionales y Ley de Colegios Profesionales de la Comunidad de Madrid).
Sus datos se conservarán mientras siga colegiado y, en todo caso, por el tiempo que estemos obligados a su conservación en cumplimiento de una obligación legal.
En cumplimiento de las leyes de colegios profesionales y los estatutos colegiales, sus datos personales podrían ser cedidos al Consejo General de Colegios Oficiales de Médicos de España y resto de organizaciones colegiales de carácter supraprovincial y, en su caso, a otras entidades públicas o privadas para la prestación de un servicio o la organización conjunta de actividades de interés para el colectivo médico; cumpliendo siempre para ello los requisitos establecidos por la legislación vigente.
La gestión de la cuota colegial conlleva, necesariamente, la comunicación de sus datos a la entidad bancaria o financiera con la que trabaja el ICOMEM para que proceda al cargo en cuenta de las cantidades adeudadas.
Para ser incluido en los seguros de vida y asistencia en viajes que el ICOMEM tiene contratados cubriendo a todos sus colegiados y beneficiarios, sus datos personales y de los beneficiarios que nos comunique serán tratados por el ICOMEM y son comunicados a las compañías aseguradoras con las que, en cada momento, se contraten las referidas pólizas. Actualmente, se tienen contratadas con las siguientes:
- Para el contrato de seguro de vida:
GENERALI ESPAÑA S.A. DE SEGUROS Y REASEGUROS , con CIF nº A28007268 y domicilio social en la C/ Orense, 2 28020
Madrid. Póliza nº G-W9-427000184.
Este seguro se comercializa bajo la mediación y dirección de este seguro se comercializa bajo la mediación de Uniteco Profesional, con CIF nº B-79325395 y docimicilio en la C/ Pez volador 22 28007 Madrid, email:
atencion.cliente@uniteco.es.
- Para el contrato de seguro de asistencia en viaje: Este seguro se comercializa bajo la mediación y dirección de Intermundial XXI, S.L. Correduría de Seguros (R.M. de Madrid, HM 180.298, S 8ª, L0, F149, T11.482. C.I.F.- B-81577231. Autorizada R.D.G.S. y F.P nº J-1541. R.C. y caución según L26/06 MSRP). La compañía aseguradora, que actúa en España a través de la agencia de suscripción MANA UW, es White Horse Insurance Ireland dac Part of Thomas Cook Group plc, company registered in Ireland No 306045. White Horse Insurance Ireland dac is regulated by the Central Bank of Ireland.
Asimismo, sus datos pueden ser cedidos a los proveedores de servicios a los que el ICOMEM recurra para, tales como servicios de correduría, siempre cumpliendo para ello los requisitos establecidos por la legislación vigente.
El tratamiento responde a la libre y legítima aceptación de una relación jurídica (colegiación) cuyo desarrollo, cumplimiento y control implica necesariamente la conexión de dicho tratamiento con ficheros de terceros, en la medida que están directamente implicados en la gestión de los seguros colectivos.
Información Paquete ICOMEM-MEDICINA PRIVADA
Además, le informamos que el ICOMEM ha negociado a favor de los nuevos médicos colegiados en Madrid que vayan a desarrollar su ejercicio libre y tengan, de acuerdo con la normativa vigente, derecho a optar entre el RETA y MUTUAL MÉDICA, los siguientes productos:
- Un producto gratuito durante el primer año con la Mutua 'Mutual Médica' que incluye un seguro de ILT, uno de asistencia en viajes, y algún servicio al colegiado de ayuda informática.
Los datos de contacto de
Mutual Médica, Mutualidad de Previsión Social a Prima Fija son los siguientes: CIF : V08475766
Domicilio Postal: Via Laietana, 31. C.P. 08003 de Barcelona
Teléfonos: 933197800
Mail:
infomutual@mutualmedica.com - DPO:
lopd@mutualmedica.com
- Un seguro de R.C. a precio fijo durante todo el periodo MIR de la Mutua PSN.
Los datos de contacto de
Previsión Sanitaria Nacional, PSN, Mutua de Seguros y Reaseguros a Prima Fija (en adelante, PSN) son los siguientes: CIF: A-78920105
Domicilio C/ Génova, nº 26, 28004 de Madrid
Teléfono: 902.100.062 y 91.061.67.90.
Mail:
informacion@grupopsn.es - D.P.D:
protecciondedatos@grupopsn.es
Si está interesado en cualquiera de estos dos productos, por favor, marque la correspondiente casilla que se facilitan, lo que supone que autoriza al ICOMEM para que pueda tratar sus datos con la finalidad de gestionar las pólizas correspondientes.
CONDICIONES DE USO DEL SERVICIO A TRAVÉS DE WHATSAPP
Mediante la aceptación de estas Condiciones de Uso, el Colegiado/interesado (en adelante, usuario) acepta la plataforma “WhatsApp”, servicio prestado por WhatsApp Ireland Limited, como canal de comunicación colegial.
Este canal permite la comunicación entre el ICOMEM y el usuario, igual que otros medios que pone el ICOMEM a disposición de cualquier Colegiado/interesado.
Para su uso, es necesario disponer de acceso a Internet móvil y tener una cuenta WhatsApp, para lo que habrá aceptado previamente las Condiciones de uso y la Política de Privacidad vigente en cada momento de esta plataforma.
El usuario solicitará a ICOMEM ser atendido por este canal, aceptando en primer lugar las presentes Condiciones de Uso. Una vez aceptadas, el usuario podrá usarlo como vía de contacto con el ICOMEM.
Se informa al usuario, que las búsquedas realizadas a través del sistema Whatsapp de comunicación colegial, emplearán terceros buscadores o motores de búsqueda externos, sin que ello signifique ceder, comunicar o compartir ningún dato de carácter personal de los usuarios con tales buscadores.
Se informa al usuario que en caso de que lo considere oportuno podrá bloquear sus comunicaciones por esta vía con el ICOMEM, empleando para ello las funcionalidades que le permita WhatsApp. También podrá solicitar a ICOMEM el dejar de ser contactado por esta vía.
Sin perjuicio de las condiciones establecidas por Whatsapp, ICOMEM informa que los datos de cualquier usuario serán tratados conforme a lo establecido en la Política de Privacidad de ICOMEM, cuya información básica se recoge en la presente cláusula.
El ICOMEM es responsable del tratamiento de los datos personales del usuario.
En ICOMEM se tratarán los datos del usuario para las finalidades y servicios que corresponden a este Colegio profesional, así como para otras finalidades que expresamente se puedan autorizar por el mismo.
Los datos personales necesarios para la finalidad expuesta obran incluidos en ficheros informatizados de datos de carácter personal titularidad de ICOMEM.
Adicionalmente a los tratamientos recogidos en la Política de Privacidad, al aceptar los presentes términos y condiciones de uso del Servicio, el usuario es informado y autoriza a ICOMEM al tratamiento específico de los datos de las conversaciones y gestiones realizadas a través de este medio de atención, cuyo tratamiento es necesario para la prestación del Servicio.
El usuario que se relacione con el ICOMEM a través de esta aplicación de mensajería instantánea debe hacerlo para los fines legales y colegiales autorizados y aceptables. El ICOMEM no se responsabiliza de los contenidos ilegales, obscenos, falsos, difamatorios, amenazantes, intimidatorios o acosadores, que inciten al odio, ofensivos, o que promuevan o fomenten conductas ilegales y/o inadecuadas. En definitiva, el ICOMEM no se hace responsable de los contenidos que se remitan al ICOMEM por esta vía ni del uso que cada usuario haga de este modo de comunicación que se pone a disposición de los usuarios. La infracción de estas condiciones de uso dará lugar a que la comunicación por este medio quede suspendida o inhabilitada a instancia del ICOMEM, sin perjuicio de las acciones legales o disciplinarias correspondientes. El ICOMEM solo recogerá y tratará estos datos mientras sean necesarios para el objeto de la comunicación, conservándolos durante el tiempo legalmente previsto para ello, especialmente teniendo en cuenta los plazos que, para la derivación de responsabilidades, las obligaciones legales exijan.
El ICOMEM no se responsabiliza del uso al que cada usuario destine los materiales puestos a disposición por esta vía ni de las actuaciones que realice en base a los mismos. Esto incluye cualquier actuación que pueda suponer una violación de cualquier tipo de norma, nacional o internacional, de los derechos de propiedad intelectual o industrial o de cualesquiera otros derechos de terceros. El ICOMEM no podrá ser considerado responsable de cualesquiera daños derivados de la utilización del presente medio de comunicación, ni por cualquier actuación realizada utilizando el contenido de la información que pueda suministrarse a través del mismo, salvo que concurra dolo o negligencia grave en sus acciones u omisiones.
El ICOMEM tendrá derecho, sin que exista indemnización alguna al Usuario, a suspender temporalmente los servicios y contenidos de este medio de comunicación para efectuar operaciones de mantenimiento, mejora o reparación del mismo. Así mismo, se adoptan medidas de seguridad razonablemente adecuadas, teniendo en cuenta el estado de la técnica en cada momento, para detectar la existencia de virus. Sin embargo, el Usuario debe tener en cuenta que las medidas de seguridad de cualquier aplicación de mensajería no son totalmente fiables y que, por tanto, no puede garantizar la inexistencia de virus u otros elementos que puedan producir alteraciones en el teléfono móvil o los sistemas del Usuario (software y hardware) o en sus documentos y ficheros electrónicos contenidos en los mismos. Derivado de lo anteriormente indicado, el ICOMEM no responde por los daños y perjuicios que tales elementos pudieran ocasionar al Usuario o a terceros.
El ICOMEM podrá modificar estas condiciones con motivo de variaciones de las características técnicas del sistema, debido a cambios tecnológicos que afecten al mismo, y por variaciones de las condiciones existentes decididas por su Junta Directiva, comunicándoselo previamente al usuario siempre que ello suponga nuevos tratamientos de datos y/o un cambio significativo de estas condiciones. Por ello, se recomienda la consulta periódica de estas condiciones. Si se continúa con la utilización de esta aplicación de mensajería instantánea, una vez comunicado el cambio, se entenderá que se está de acuerdo con el mismo.
Por otro lado, para cualquiera de las finalidades previstas en la Política de Privacidad, ICOMEM podrá encargar su tratamiento a proveedores de confianza. La relación actualizada de las categorías de dichos proveedores, así como de aquellos que realizan transferencias internacionales de datos en el ejercicio de sus funciones, obra en la web del ICOMEM. Asimismo, ICOMEM garantiza la adopción de las medidas necesarias para asegurar el tratamiento confidencial de dichos datos y le informa de la posibilidad de ejercitar, conforme a dicha normativa, los derechos de acceso, rectificación, supresión, limitación, oposición y portabilidad, dirigiendo un escrito a la dirección de correo electrónico
protecciondatos@icomem.es.
EJERCICIO DE DERECHOS
Como titular de los datos personales, puede ejercitar los siguientes derechos:
- Derecho a retirar el consentimiento prestado para el tratamiento de sus datos personales con fines informativos en cualquier momento
- Derecho de acceso a la información que se trata sobre su persona
- Derecho de rectificación de sus datos, en caso de que resultaran inexactos o incompletos
- Derecho de supresión, cuando, entre otros motivos, sus datos ya no sean necesarios para los fines que fueron recogidos
- Derecho de oposición al tratamiento de sus datos con fines informativos
- Derecho de limitación del tratamiento cuando, entre otras condiciones, se solicite la rectificación u oposición al tratamiento
- Derecho a la portabilidad de los datos que haya facilitado en un formato estructurado, de uso común y lectura mecánica;
Para ello, puede remitir solicitud por escrito, en la que debe hacer constar el derecho que quiere ejercitar, su nombre y apellidos, dirección a efectos de notificaciones, junto con una copia de su DNI u otro documento válido que acredite su identidad, dirigida al Delegado de Protección de Datos del Ilustre Colegio Oficial de Médicos de Madrid, en la dirección postal C/ Santa Isabel, 51, CP 28012 de Madrid, o en la dirección de correo electrónico
protecciondatos@icomem.es
Asimismo, le asiste el derecho a presentar una reclamación ante la Agencia Española de Protección de Datos (
www.agpd.es) si considera que el tratamiento no se ajusta a la normativa vigente o no ha obtenido satisfacción en el ejercicio de sus derechos.